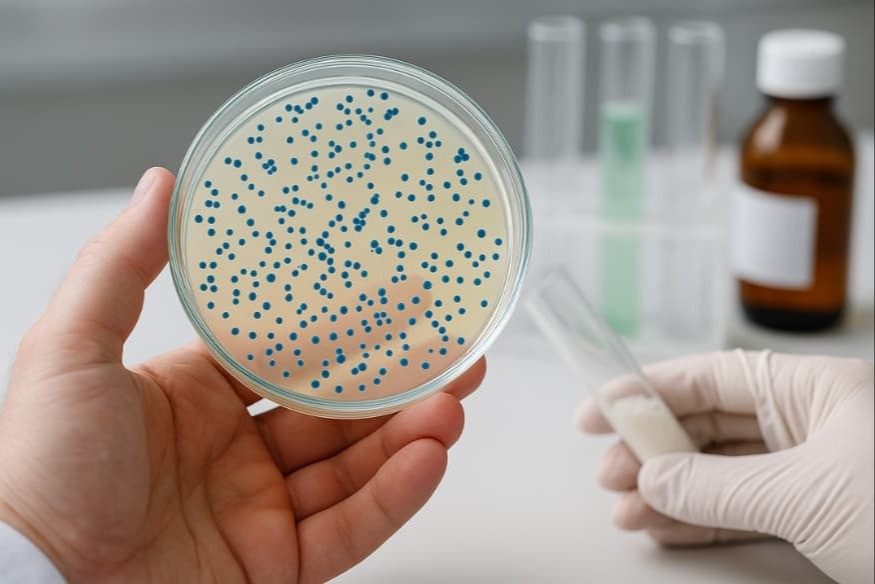

02 juin 2025
L’Autorité européenne de sécurité des aliments rend un avis favorable sur la souche Clostridium butyricum TO-A en tant que nouvel aliment. Cette évaluation, déposée en 2022 par le laboratoire japonais TOA Biopharma, s’inscrit dans le cadre du règlement européen sur les nouveaux aliments. Cette souche probiotique, producteur de butyrate, est jugée sans risque lorsqu’elle est utilisée dans les compléments alimentaires, sous réserve de respecter des dosages précis par tranche d’âge : cent millions d’UFC par jour pour les enfants de 3 à 10 ans, jusqu’à trois cent vingt millions d’UFC pour les adultes. Les femmes enceintes et allaitantes restent exclues, faute de données suffisantes. La société a par ailleurs sollicité une protection de ses données selon l’article 26 du règlement européen, renforçant ainsi l'exclusivité de son dossier technique.

























%20(875%20x%20584%20px)%20(400%20x%20400%20px)%20(3)%20(2).jpg)